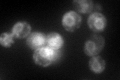
YPL274W
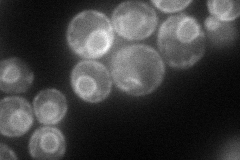
YPL274W
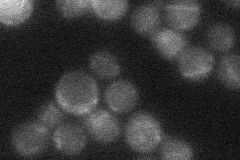
YPL274W
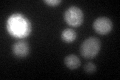
YPL274W
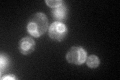
YPL274W
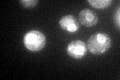
YPL274W

View description
High-affinity S-adenosylmethionine permease, required for utilization of S-adenosylmethionine as a sulfur source; has similarity to S-methylmethionine permease Mmp1p
Localization:
Intensity:
Fold change:
Significance:
-
C’ GFP library in SD
ER114.47 -
N' NOP1pr-GFP in SD
ER100.874 -
N' TEF2pr-mCherry in SD

ER,vacuole92.2402 -
N' NATIVEpr-GFP in SD
below threshold19.3011 -
N' TEF2pr-VC and Cyto-VN in SD

cell periphery40.9645 -
C’ GFP library in SD+DTT
ER37.890.33Yes -
C’ GFP library in SD+H2O2
ER99.210.86No -
C’ GFP library in Starvation Media
ER113.160.98No -
C’ GFP library on the background of Pup2-DaMP

ER -
C’ GFP library on the background of CCT mutant

ER79.44180.693965No
